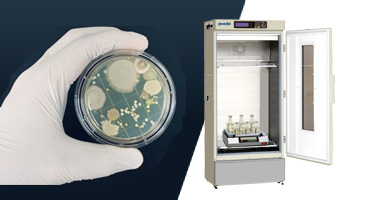

PHCbiはお客様のニーズに合わせて開発と研究をサポート
細菌、酵母、カビだけでなく、藻類のような光合成を行う微生物、偏嫌気性菌のような特殊な環境を必要とする研究もあれば、
再生医療に関わる研究、組織の細胞を再生する培養肉(細胞肉)などの先端の研究まで研究開発に関わる生物種は多様化しております。
PHCbiの低温インキュベーターは、お客様のニーズに合わせて、温度管理・培養環境に対応可能なラインナップを取り揃えております。
無料ダウンロードe-book 「食品微生物学の知見をHACCPに活用するために」

HACCP(Hazard Analysis Critical Control Point)は、1960年代後半に米国で初めて開発されました。NASA(米国航空宇宙局)は、米国陸軍研究所とピルズベリー社と共同で、宇宙ミッションのための食品安全管理システムを開発しました。このシステムの基礎となったCCP(Critical Control Point)ガイドラインは、兵器の設計・試験に用いられていたシステムと同様に、システムの故障やリスクのある部分を特定して排除することを目的としています。NASAの成功を受けて、HACCPシステムは、製造業、農業、水産業、小売業など、さまざまな食品産業に好影響を与えています。このe-bookでは、HACCPの定義と目的、そして日本をはじめとするAPAC諸国の食品事業者にとってのHACCPのメリットを簡単に紹介します。
ダウンロード